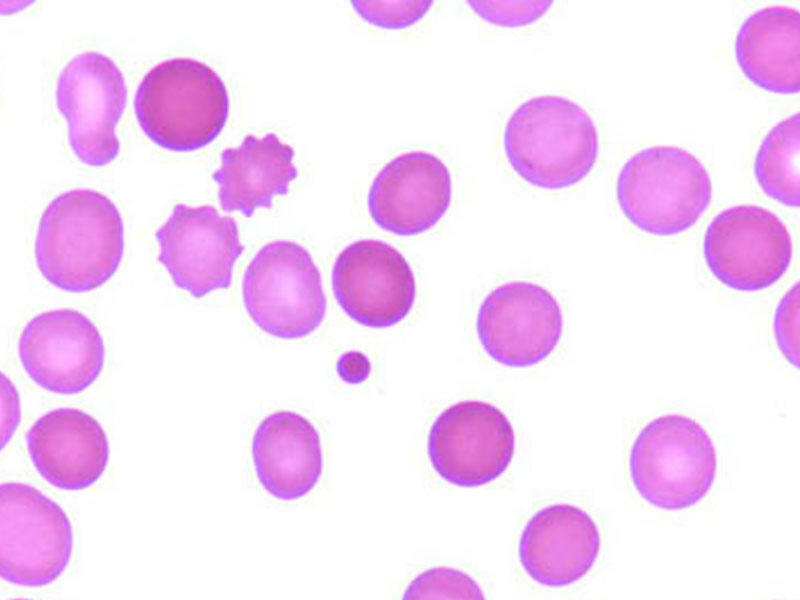
İrsi mikrosferositoz

İrsi mikrosferositoz
İrsi mikrosferositoz hemolitik anemiyanın əsasında autosom dominant tipli, irsən keçən, eritrositlərin membranının defisiti durur. Eritrositlər sferik formada olduğundan kiçik kaprilyarlardan və xüsusən də dalağın sinuslarından keçən zaman formasını dəyişdirə bilmir, nəticədə eritrositin membranından bir hissəsi itir və hemoliz baş verir. Eritrositin membranı daxilə artıq miqdarda Na ionları buraxır və balansını saxlamaq üçün eritrosit daha çox miqdarda ATF və qlükoza sərf edir. Bu da öz növbəsində eritrositlərin ömrünün qısalmasına səbəb olur. Digər tərəfdən dalaqda makrofaqlar sferositləri faqositoz edərək qan dövranından kənarlaşdırır ki, bu da anemiyanın əsas səbəbi sayılır.
İrsi mikrosferositoz hemolitik anemiyanın əsasında autosom dominant tipli, irsən keçən, eritrositlərin membranının defisiti durur. Eritrositlər sferik formada olduğundan kiçik kaprilyarlardan və xüsusən də dalağın sinuslarından keçən zaman formasını dəyişdirə bilmir, nəticədə eritrositin membranından bir hissəsi itir və hemoliz baş verir. Eritrositin membranı daxilə artıq miqdarda Na ionları buraxır və balansını saxlamaq üçün eritrosit daha çox miqdarda ATF və qlükoza sərf edir. Bu da öz növbəsində eritrositlərin ömrünün qısalmasına səbəb olur. Digər tərəfdən dalaqda makrofaqlar sferositləri faqositoz edərək qan dövranından kənarlaşdırır ki, bu da anemiyanın əsas səbəbi sayılır.
Xəstəlik özünü hemolitik sindrom və anadangəlmə sklet və daxili orqanların anormallığı ilə göstərirr. Xəstəlik dalğavari keçir, hemolitik krizlə vaxtaşırı təkrarlanır.
Xəstəliyin əlamətləri aşağıdakılardır:
- dəridə sarılıq
- zəiflik
- tez yorulma
- titrəmə.
Xəstəliyin ağır vəziyyətlərində soyuqdəymə nəticəsində də kriz baş verə bilir.
Bu zaman xəstədə temperatur yüksəlir, əzələlər, qaraciyər və dalaq nahiyyədə ağrılar baş verir. Sarılıq əlamətləri güclənir, sidiyin və nəcisin rəngi tündləşir. Belə olduqda xəstəni xəstəxana şəraitində müalicə etmək lazım gəlir. Xəstəlik irsi xarakter daşıdığından belə xəstələr anadangəlmə qüsurlu doğulurlar.
Diaqnoz qanın ümumi, biokimyəvi laborator analizlərinə əsasən qoyulur.
Müalicə dalağın orqanizmdən xaric olunmasından ibarətdir. Bu əməliyyatdan sonra eritrositlərin deffektli qalmasına baxmayaraq, hemoliz dayanır. Xəstələrə dəmir preparatları, B12 təyin edilir.
Milli.Az










 Hakışta
Hakışta Cəfərinin insan orqanizminə inanılmaz faydaları
Cəfərinin insan orqanizminə inanılmaz faydaları Mükəmməl seks üçün yataqdakı QAYDALAR
Mükəmməl seks üçün yataqdakı QAYDALAR DİQQƏT ! Yuxuda pişik görmüsüzsə ..Ağır xəstəlik gözləyir
DİQQƏT ! Yuxuda pişik görmüsüzsə ..Ağır xəstəlik gözləyir Kondisioneri neçə dərəcədə işlətmək daha düzgündür?
Kondisioneri neçə dərəcədə işlətmək daha düzgündür? İsti havada çimərliyə bu qidaları aparmaq olmaz
İsti havada çimərliyə bu qidaları aparmaq olmaz İşdə nə edək ki, daha az yorulaq
İşdə nə edək ki, daha az yorulaq Enerji içkisi sevənlər oxusun
Enerji içkisi sevənlər oxusun Çılpaq yatmağın faydaları
Çılpaq yatmağın faydaları Sağlam qaraciyər üçün qəhvə için
Sağlam qaraciyər üçün qəhvə için Fatih Terim azərbaycanlı müğənni ilə bir arada — FOTOLAR
Fatih Terim azərbaycanlı müğənni ilə bir arada — FOTOLAR Hər gün etdiyiniz bir vərdiş həyatınızı xilas edə bilər
Hər gün etdiyiniz bir vərdiş həyatınızı xilas edə bilər Uzun müddət oturmaq ölüm riskini artırır
Uzun müddət oturmaq ölüm riskini artırır Arıqlamağa mane olan 3 böyük səhv
Arıqlamağa mane olan 3 böyük səhv